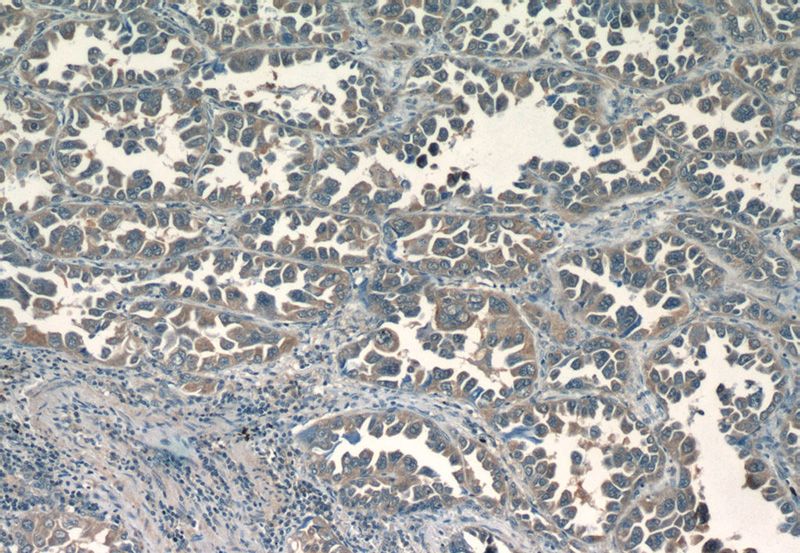
Immunohistochemistry of paraffin-embedded human lung cancer tissue slide using Catalog No:107511(RRM1 Antibody) at dilution of 1:50
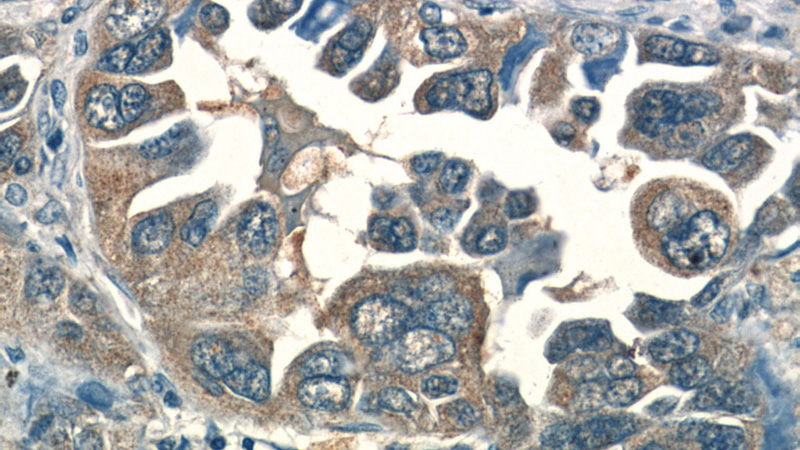
Immunohistochemistry of paraffin-embedded human lung cancer tissue slide using Catalog No:107511(RRM1 Antibody) at dilution of 1:50

-
Product Name
RRM1 antibody
- Documents
-
Description
RRM1 Mouse Monoclonal antibody. Positive FC detected in HepG2 cells. Positive IHC detected in human lung cancer tissue, human breast cancer tissue, human cervical cancer tissue, human ovary tumor tissue. Positive IP detected in K-562 cells. Positive WB detected in K-562 cells. Observed molecular weight by Western-blot: 90 kDa
-
Tested applications
ELISA, FC, IP, WB, IHC
-
Species reactivity
Human, Mouse; other species not tested.
-
Alternative names
ribonucleotide reductase M1 antibody; RIR1 antibody; RR1 antibody; RRM1 antibody
-
Isotype
Mouse IgG1
-
Preparation
This antibody was obtained by immunization of RRM1 recombinant protein (Accession Number: NM_001033). Purification method: Caprylic acid/ammonium sulfate precipitation.
-
Clonality
Monoclonal
-
Formulation
PBS with 0.1% sodium azide and 50% glycerol pH 7.3.
-
Storage instructions
Store at -20℃. DO NOT ALIQUOT
-
Applications
Recommended Dilution:
WB: 1:200-1:2000
IP: 1:500-1:5000
IHC: 1:20-1:200
-
Validations

K-562 cells were subjected to SDS PAGE followed by western blot with Catalog No:107511(RRM1 antibody) at dilution of 1:500

IP Result of anti-RRM1 (IP:Catalog No:107511, 5ug; Detection:Catalog No:107511 1:1000) with K-562 cells lysate 3200ug.
Immunohistochemistry of paraffin-embedded human lung cancer tissue slide using Catalog No:107511(RRM1 Antibody) at dilution of 1:50
Immunohistochemistry of paraffin-embedded human lung cancer tissue slide using Catalog No:107511(RRM1 Antibody) at dilution of 1:50

1X10^6 HepG2 cells were stained with .2ug RRM1 antibody (Catalog No:107511, red) and control antibody (blue). Fixed with 90% MeOH blocked with 3% BSA (30 min). Alexa Fluor 488-congugated AffiniPure Goat Anti-Mouse IgG(H+L) with dilution 1:1000.
-
Background
Ribonucleoside-diphosphate reductase functions as a heterodimer of a large and a small subunits in deoxyribonucleotide synthesis. RRM1 constitutes to the large subunit (R1) of ribonucleotide reductase, and it can either form heterodimer with small subunit RRM or RRM2B. RRM1 provides the precursors necessary for DNA synthesis. RRM1 can not be detected in quiescent cells, while its mRNA and protein are present throughout the cell cycle in cycling cells(PMID:8188248). Researches showed that RRM1 is involved in carcinogenesis, tumor progression, and the resistance of non-small-cell lung cancer (NSCLC) to treatment. Low level expression of RRM1 in NSCLC is associated with poor survival(PMID:17314339).
-
References
- Lv C, Ma Y, Feng Q. A pilot study: sequential gemcitabine/cisplatin and icotinib as induction therapy for stage IIB to IIIA non-small-cell lung adenocarcinoma. World journal of surgical oncology. 11:96. 2013.
Related Products / Services
Please note: All products are "FOR RESEARCH USE ONLY AND ARE NOT INTENDED FOR DIAGNOSTIC OR THERAPEUTIC USE"
